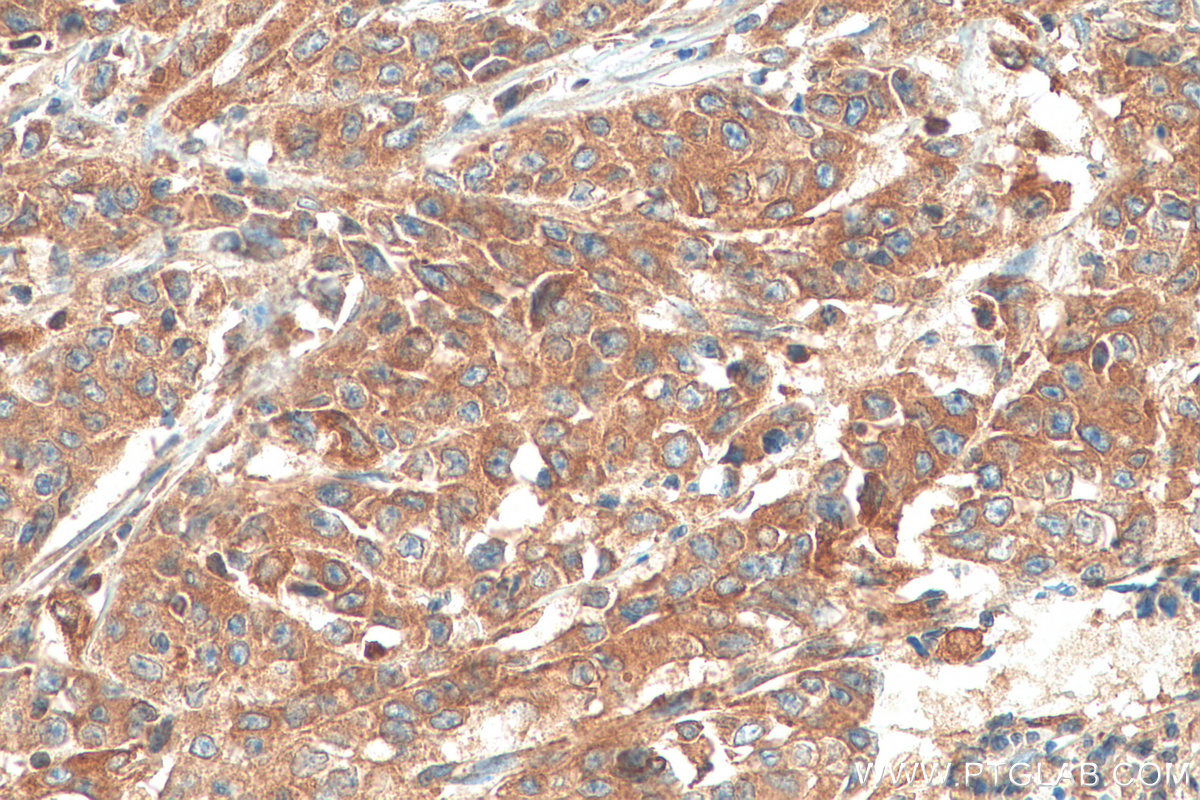
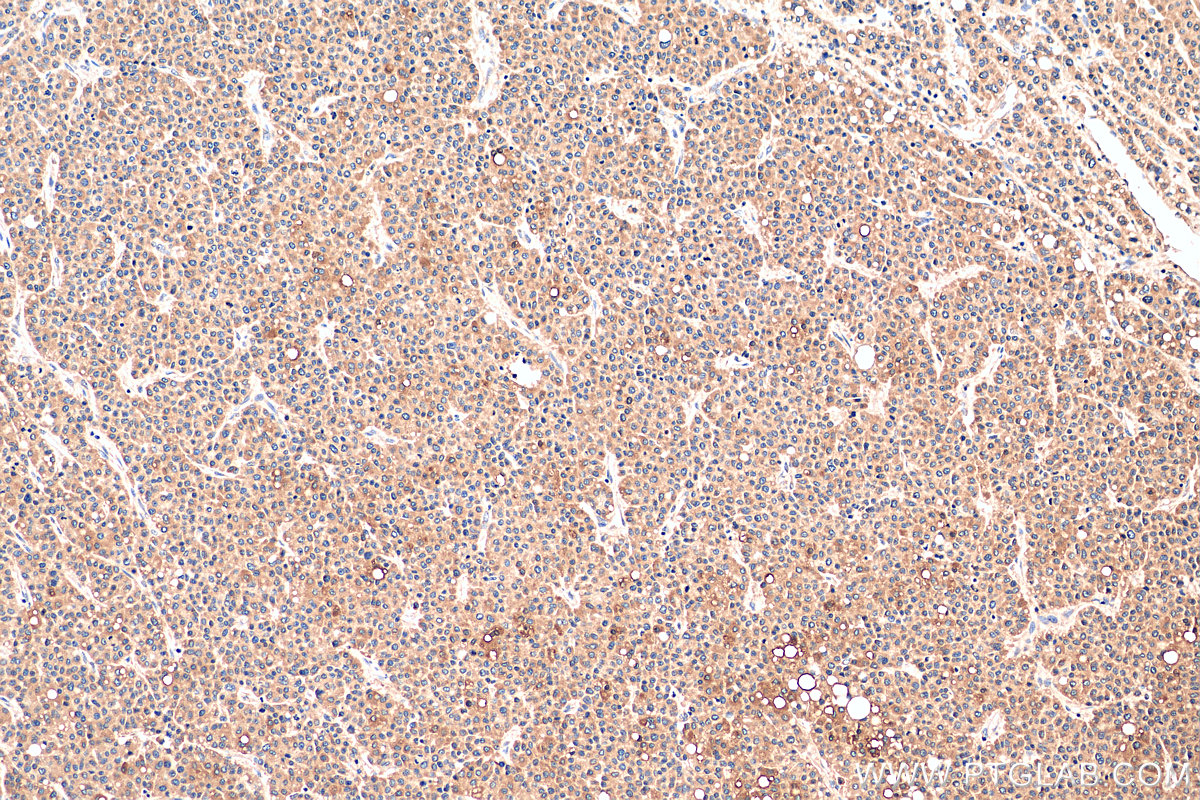

验证数据展示
经过测试的应用
| Positive WB detected in | HeLa cells, HepG2 cells, L02 cells, U-87 MG cells, HT-29 cells, NIH/3T3 cells, HSC-T6 cells |
| Positive IP detected in | HeLa cells |
| Positive IHC detected in | human liver cancer tissue, human stomach cancer tissue, rat brain tissue Note: suggested antigen retrieval with TE buffer pH 9.0; (*) Alternatively, antigen retrieval may be performed with citrate buffer pH 6.0 |
推荐稀释比
| 应用 | 推荐稀释比 |
|---|---|
| Western Blot (WB) | WB : 1:5000-1:50000 |
| Immunoprecipitation (IP) | IP : 0.5-4.0 ug for 1.0-3.0 mg of total protein lysate |
| Immunohistochemistry (IHC) | IHC : 1:50-1:500 |
| It is recommended that this reagent should be titrated in each testing system to obtain optimal results. | |
| Sample-dependent, Check data in validation data gallery. | |
发表文章中的应用
| WB | See 8 publications below |
| IHC | See 1 publications below |
产品信息
81196-1-RR targets ACSL4/FACL4 in WB, IHC, IP, ELISA applications and shows reactivity with human, mouse, rat samples.
| 经测试应用 | WB, IHC, IP, ELISA Application Description |
| 文献引用应用 | WB, IHC |
| 经测试反应性 | human, mouse, rat |
| 文献引用反应性 | human, mouse, rat |
| 免疫原 |
CatNo: Ag18085 Product name: Recombinant human ACSL4 protein Source: e coli.-derived, PET28a Tag: 6*His Domain: 143-236 aa of BC034959 Sequence: LGKEAVVHGLNESEASYLITSVELLESKLKTALLDISCVKHIIYVDNKAINKAEYPEGFEIHSMQSVEELGSNPENLGIPPSRPTPSDMAIVMY 种属同源性预测 |
| 宿主/亚型 | Rabbit / IgG |
| 抗体类别 | Recombinant |
| 产品类型 | Antibody |
| 全称 | acyl-CoA synthetase long-chain family member 4 |
| 别名 | ACSL4, FACL4, 3I9, ACS4, ACSL 4 |
| 计算分子量 | 711 aa, 79 kDa |
| 观测分子量 | 70 kDa, 75 kDa |
| GenBank蛋白编号 | BC034959 |
| 基因名称 | ACSL4 |
| Gene ID (NCBI) | 2182 |
| RRID | AB_2923707 |
| 偶联类型 | Unconjugated |
| 形式 | Liquid |
| 纯化方式 | Protein A purification |
| UNIPROT ID | O60488 |
| 储存缓冲液 | PBS with 0.02% sodium azide and 50% glycerol, pH 7.3. |
| 储存条件 | Store at -20°C. Stable for one year after shipment. Aliquoting is unnecessary for -20oC storage. |
背景介绍
Acyl-CoA synthetase long-chain family member 4 (Acsl4), an important enzyme involved in lipid metabolism, participates in ferroptosis by converting free AA into arachidonoyl-CoA to generate lipid hydroperoxides. Recent studies revealed that ACSL4 is involved in biological responses including inflammation, steroidogenesis, cell death, female fertility, and cancer. Acsl4 has two isoforms: 79 kDa and 75 kDa. ACSL4 also can be detected in 70 kDa(PMID:35326233).
实验方案
| Product Specific Protocols | |
|---|---|
| IHC protocol for ACSL4/FACL4 antibody 81196-1-RR | Download protocol |
| IP protocol for ACSL4/FACL4 antibody 81196-1-RR | Download protocol |
| WB protocol for ACSL4/FACL4 antibody 81196-1-RR | Download protocol |
| Standard Protocols | |
|---|---|
| Click here to view our Standard Protocols |
发表文章
| Species | Application | Title |
|---|---|---|
Front Pharmacol Epigallocatechin gallate alleviates high-fat diet-induced hepatic lipotoxicity by targeting mitochondrial ROS-mediated ferroptosis | ||
Nanomedicine (Lond) Mesoporous zinc-polyphenol nanozyme for attenuating renal ischemia-reperfusion injury | ||
BMC Cancer Oridonin-induced ferroptosis and apoptosis: a dual approach to suppress the growth of osteosarcoma cells | ||
J Cardiovasc Transl Res Hypoxia Aggravates Myocardial Ischemia/Reperfusion Injury Through the Promotion of Ferroptosis via ACSL4 Lactylation | ||
MedComm (2020) Novel aspect of neprilysin in kidney fibrosis via ACSL4-mediated ferroptosis of tubular epithelial cells | ||
Eur J Pharm Sci Pharmacodynamic Insights into Maresin 1: Enhancing Flap Viability via the Keap1/Nrf2 Axis to Control ROS-Driven Apoptosis and Ferroptosis |